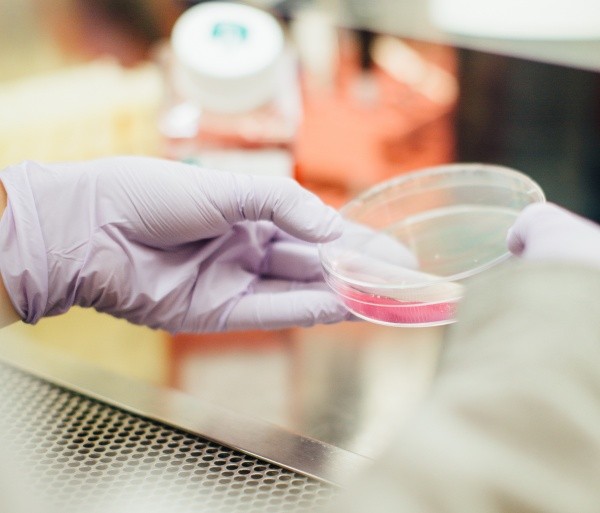

Ученые в российских и зарубежных университетах выявили новую супергруппу хищных бактерий, способных откусить часть клетки своей жертвы. Особые существа отделились от основной группы примерно миллиард лет назад.
Как рассказали в ТАСС, ссылаясь на пресс-центр МГУ, новые одноклеточные организмы назвали Provona. С помощью специального жгутика они могут быстро двигаться в среде. Помимо этого, у клеток есть специальная лента из микротрубок, которая служит им хищным ртом. Provona устраивают охоту даже на клетки с большими размерами.
Как показал генетический анализ, Provona нельзя отнести к известным видам эукариотов. Исследователи считают, что они отделились от основной группы примерно миллиард лет назад. С тех пор они использовали хищническую стратегию для обеспечения выживания.
Ранее «Марийская правда» сообщала, что учеными был раскрыт механизм появления ряби на льду. Кроме того, до падения астероида Чиксулуб эра динозавров была на подъеме.